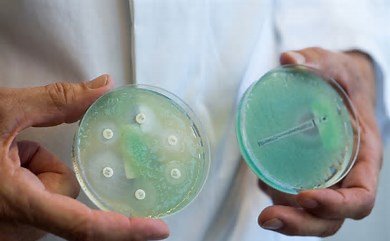
th (1)

Bastaron 200 años, apenas un microsegundo en la línea temporal de la humanidad, para que las bacterias Pseudomonas aeruginosa pasasen de ser unos inofensivos microbios que habitaban charcas, arroyos y plantas, a convertirse en una de las grandes amenazas infecciosas del planeta. Causantes de más de 500.000 muertes al año, estos bacilos están hoy en la lista negra de la Organización Mundial de la Salud como un patógeno de “alta prioridad” por su resistencia a los antibióticos y su amplia expansión por el globo. Una investigación publicada este jueves en la revista Science ha mapeado el periplo genómico de esta especie bacteriana y ha descubierto que las P. aeruginosa aprovechan un defecto inmunológico en los pacientes con fibrosis quística para sobrevivir y perpetuarse.
“Durante los últimos 200 años, aproximadamente, determinadas bacterias individuales, a las que llamamos clones, lograron absorber nuevos genes y volverse más capaces de infectar a los humanos. Estos clones luego se expandieron y se extendieron por todo el mundo. La fecha de expansión más probable para el primer clon es alrededor de 1890, aunque el intervalo de confianza es amplio”, explica el científico Andrés Floto, profesor de Biología Respiratoria de la Universidad de Cambridge y autor del estudio. A esas ramas familiares del árbol genealógico de las P. aeruginosa que se dispersan por el mundo, los autores los llaman “clones epidémicos”. El estudio encontró unos 21 que son responsables de más del 50% de todas las infecciones por P. aeruginosa en el planeta. “Es probable que sean los principales impulsores de la resistencia a los antibióticos y de las muertes”, reflexiona el investigador en una respuesta por correo electrónico.
Esa malignidad que muestra ahora la P. aeruginosa es relativamente joven. Tras explorar el árbol genealógico de esta especie, los autores conjeturan con todas las cautelas que el punto de partida de todo este fenómeno es a finales del siglo XVIII. “Es poco probable que antes de esa fecha hubieran supuesto una amenaza importante para la salud humana”, conviene Floto.
Desde principios del siglo XIX, apunta el investigador, “ha habido una aparición cada vez más frecuente de estos clones epidémicos”. Los autores creen que cada uno de ellos experimentó al menos una expansión poblacional relevante entre 1850 y el 2000. “Han surgido de forma aleatoria en todo el mundo, pero parecen expandirse cada vez con más frecuencia. Por ejemplo: de 1900 a 1950 surgieron seis clones epidémicos; y entre 1950 y el 2000, aparecieron 12″, ejemplifica Floto.
Esos fenómenos de expansión global entre humanos, cuenta el científico, se siguen sucediendo de forma cada vez más habitual: “Estamos viendo cada vez más clones epidémicos surgiendo y propagándose por todo el mundo, lo que creemos que puede deberse a la contaminación del aire y la densidad de viviendas”. Los autores sugieren que la propagación de estas familias bacterianas más agresivas se aceleró con la sobrepoblación en las ciudades, producto de los movimientos migratorios a las grandes urbes durante la industrialización: ahí se gestó un caldo de cultivo con áreas densamente pobladas y un incremento de la polución que provocó una mayor susceptibilidad a las infecciones y más facilidad de expansión de estos cuadros infecciosos.
Hoy, las P. aeruginosa se han convertido en patógenos oportunistas. Esto significa que no dañan a personas sanas, pero sí causan infecciones pulmonares y sistémicas en individuos que tienen su sistema inmunológico comprometido. Por ejemplo, personas con enfermedad pulmonar obstructiva crónica (EPOC) o fibrosis quística. Se han reportado infecciones a causa de esta bacteria entre pacientes ingresados en ambientes hospitalarios (infecciones nosocomiales), pero también en entornos comunitarios. Está en el punto de mira de todas las autoridades sanitarias, explica Bruno González-Zorn, director de la Unidad de Resistencias Antimicrobianas de la Universidad Complutense de Madrid y asesor de la Organización Mundial de la Salud (OMS) en este campo: “Es muy importante. Tiene una extraordinaria capacidad de adaptación a muchos ecosistemas y lo que nos preocupa tanto es su nivel de resistencia a los antibióticos y la cantidad de pacientes que mata al año”
Tras analizar cerca de 10.000 muestras humanas, animales y ambientales de este microorganismo, los investigadores de Cambridge lograron trazar la historia familiar de las P. aeruginosa, pero también identificaron un mecanismo de tolerancia bacteriana que puede ser clave para entender su resistencia. En muestras de pacientes con fibrosis quística, los científicos descubrieron que los macrófagos, que son unas células inmunes encargadas de engullir y matar a los microorganismos nocivos, no eran capaces de eliminar a las P. aeruginosa: estos clones lograban sobrevivir dentro de los macrófagos y establecer una infección persistente.
Los científicos creen que la capacidad de algunos clones epidémicos de sobrevivir a los macrófagos es una combinación de la genética de la bacteria — identificaron un gen involucrado— y un fallo en la línea de defensa del organismo de una persona con fibrosis quística. “La bacteria aprovecha este defecto inmunológico para infectar a este grupo de pacientes”, apunta Floto.
Más virulentas y efectivas
En ese tránsito generacional infectando a humanos, estas bacterias han ido evolucionando, adaptándose a través de mutaciones de su ADN, para volverse más efectivas para infectar el pulmón y más virulentas para resistir el azote de los antibióticos. Otro hallazgo de estos investigadores es que esas múltiples rondas de adaptación al pulmón y posterior transmisión a otra persona, ocurrieron de forma diferente para las bacterias que infectan a pacientes con fibrosis quística en comparación con los bacilos que atacan a personas que no tienen esta enfermedad. “La bacteria se vuelve cada vez más especializada y ciertos clones continúan transmitiéndose entre pacientes con fibrosis quística, mientras que otros clones se transmiten entre pacientes sin esta enfermedad. Pero estos clones bacterianos especializados pierden la capacidad de transmitirse de pacientes con fibrosis quística a enfermos sin ella, y viceversa”, apunta.
María del Mar Tomás, microbióloga del Complexo Hospitalario Universitario de A Coruña y portavoz de la Sociedad Española de Infecciosas y Microbiología Clínica (SEIMC), destaca la importancia de esta investigación, en la que no ha participado, para profundizar en el conocimiento de los mecanismos de tolerancia y resistencia bacteriana. Estos sistemas moleculares ayudan al bacilo a sobrevivir al estrés. “Esto es muy importante porque son mecanismos globales, que se activan ante cualquier situación de estrés de la bacteria, como el hambre o un antibiótico. Y esto puede ser una diana terapéutica para el diseño de nuevas terapias”. En la misma línea se pronuncia González-Zorn: “Es un estudio relevante porque nos permite conocer la trayectoria evolutiva de la bacteria y cómo consigue establecer estrategias para producir enfermedad. Si conocemos esos mecanismos podremos diseñar estrategias de contención de esta bacteria”.
Los autores, por su parte, advierten de que sus hallazgos ponen de relieve “la importancia de la vigilancia global y la prevención de infecciones cruzadas para evitar la aparición de futuros clones epidémicos”. “Tenemos indicios de que los clones epidémicos se adaptarán cada vez más al pulmón humano y serán cada vez más resistentes a los antibióticos si se les permite continuar este ciclo de infección, adaptación y transmisión”, avisa Floto.
Ante la velocidad de aparición de clones epidémicos, el investigador insta a buscarlos activamente para evitar que se propaguen y también detectar rápido la bacteria en los pulmones para erradicarla cuanto antes. En este sentido, si bien hay medidas de control para prevenir la infección por P. aeruginosa en fibrosis quística, el científico recuerda que sus resultados muestran que la transmisión entre humanos “también ocurre con mucha frecuencia en personas sin fibrosis quística”, lo que obliga a plantear cómo proteger a estos otros grupos de riesgo.